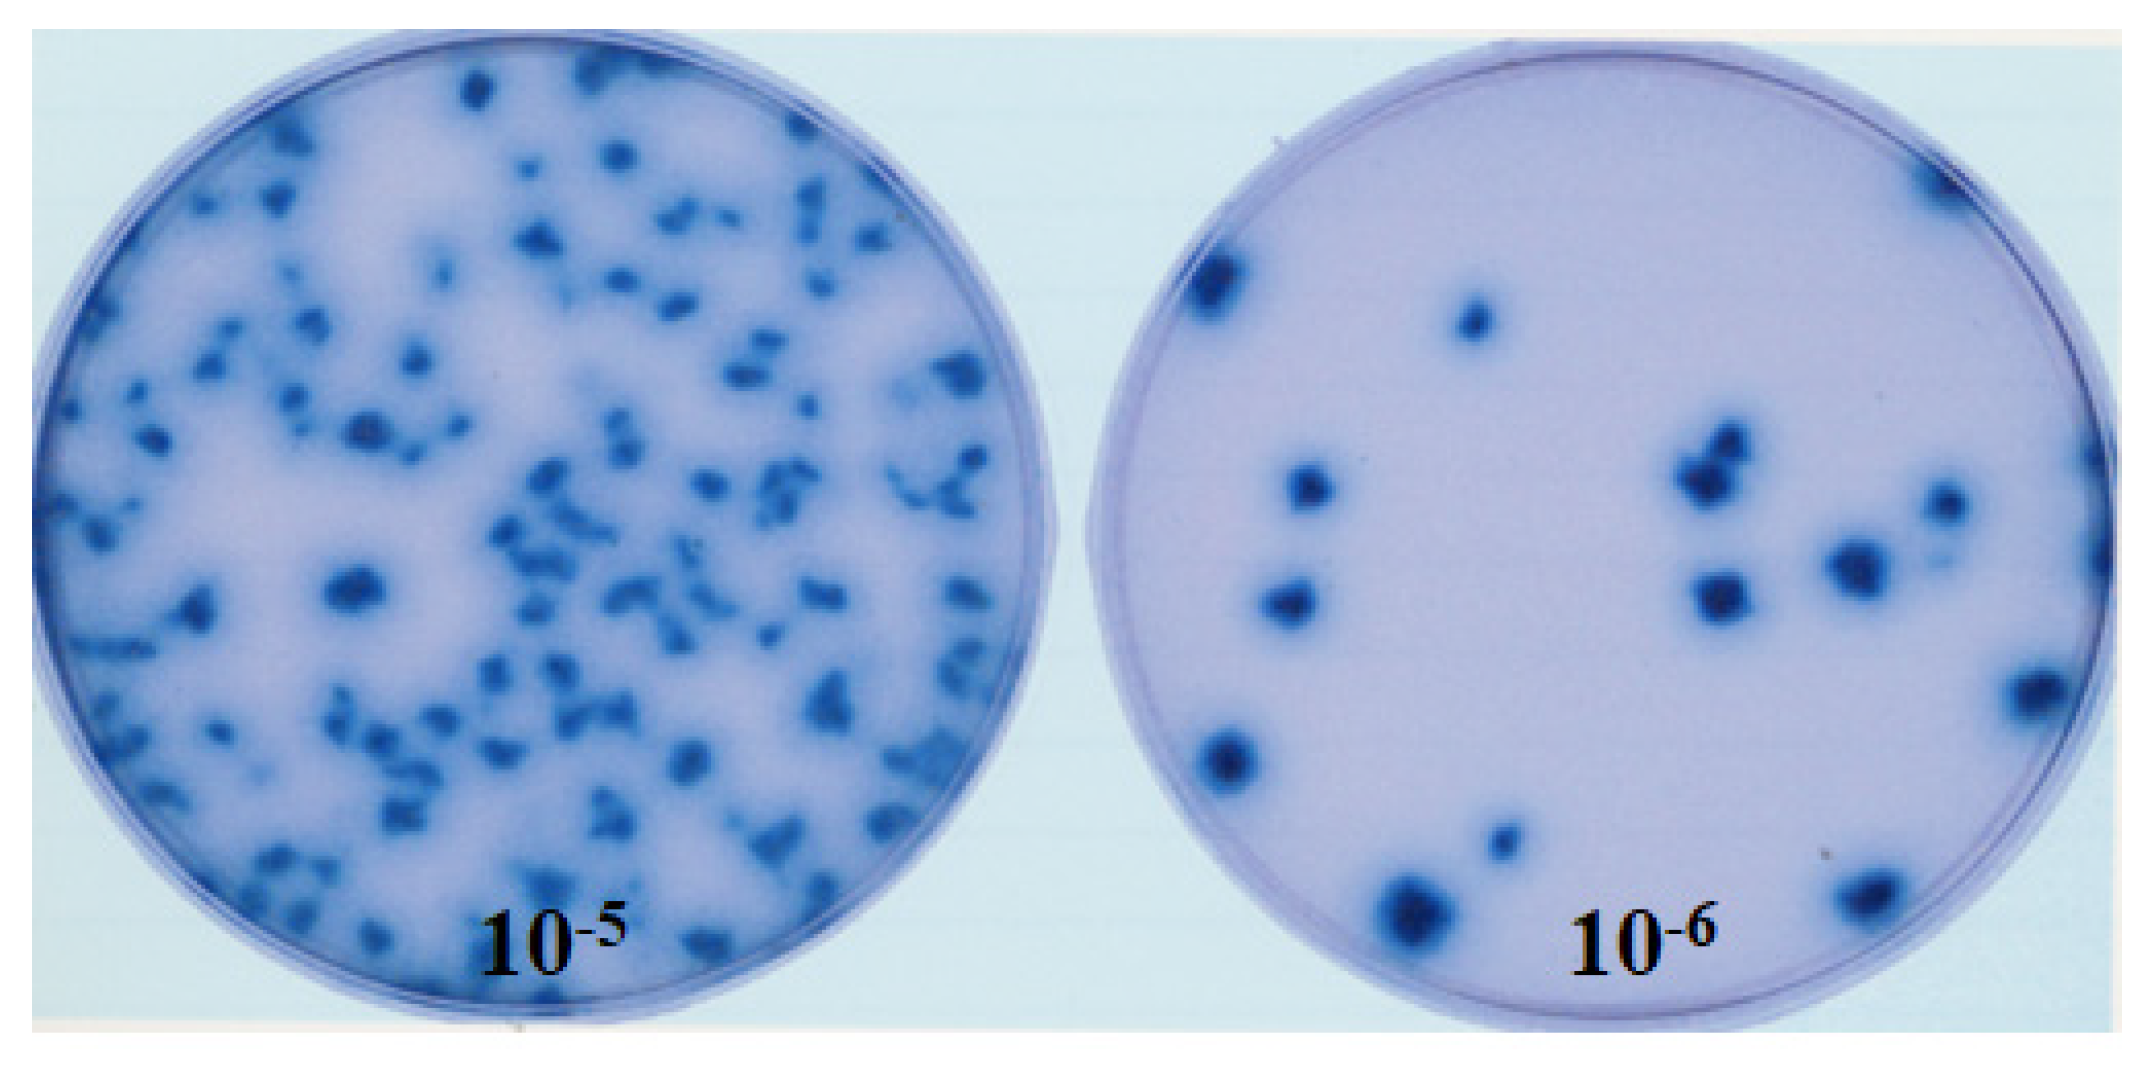
Preprints 85537 g002

Submitted:
19 September 2023
Posted:
19 September 2023
You are already at the latest version
Abstract
Keywords:
1. Introduction
2. Materials and Methods
2.1. Chickens
2.2. Viruses
2.3. Generation of novel fpIBD1 recombinants
2.4. Experimental design
2.5. Sample processing
2.5.1. RNA extraction
2.5.2. Frozen sections for immunohistochemical staining
2.5.3. H&E staining
2.6. Real-time quantitative RT-PCR
2.7. Construction of standard curves for quantitative PCR and RT-PCR assays
3. Results
3.1. Protection from IBDV challenge by the recombinant vaccine fpIBD1 and the new viral constructs
3.2. Detection of IBDV using immunohistochemistry
3.3. Detection of IBDV using real-time quantitative RT-PCR
4. Discussion
5. Conclusions
Author Contributions
Funding
Institutional Review Board Statement
Data Availability Statement
Acknowledgments
Conflicts of Interest
References
- Cosgrove, A. An apparently new disease of chickens - Avian Nephrosis. Avian Dis. 1962;6:385-389.
- Eterradossi, N, Saif YM. Infectious bursal disease. In: David E. Swayne, Martine Boulianne, Catherine M. Logue, Larry R. McDougald, Venugopal Nair, David L. Suarez, Sjaak de Wit, Tom Grimes, Deirdre Johnson, Michelle Kromm, Teguh Yodiantara Prajitno, Ian Rubinoff, Guillermo Zavala, Eds. Diseases of Poultry. By John Wiley & Sons, Inc. 14th ed. 2020: pp: 257-283.
- Gao H, Wang Y, Gao L, Zheng SJ. Genetic Insight into the Interaction of IBDV with Host-A Clue to the Development of Novel IBDV Vaccines. Int J Mol Sci. 2023 May 4;24(9):8255. 4 May. [CrossRef]
- Van der Berg TP, Gonze M, Meulemans G. Acute infectious bursal disease in poultry: isolation and characterisation of a highly virulent strain. Avian Pathol. 1991;20:133-143. [CrossRef]
- Hein R, Koopman R, García M, Armour N, Dunn JR, Barbosa T, Martinez A. Review of Poultry Recombinant Vector Vaccines. Avian Dis. 2021 Sep;65(3):438-452. [CrossRef]
- Taylor J, Edbauer C, Rey SA, Bouquet JF, Norton E, Goebel S, et al. Newcastle disease virus fusion protein expressed in a fowlpox virus recombinant confers protection in chickens. J. Virol. 1990;64:1441-1450. [CrossRef]
- Criado MF, Bertran K, Lee DH, Killmaster L, Stephens CB, Spackman E, Sa E Silva M, Atkins E, Mebatsion T, Widener J, Pritchard N, King H, Swayne DE. Efficacy of novel recombinant fowlpox vaccine against recent Mexican H7N3 highly pathogenic avian influenza virus. Vaccine. 2019 Apr 10;37(16):2232-2243. [CrossRef]
- Qingzhong Y, Barrett T, Brown TD, Cook JK, Green P, Skinner MA, et al. Protection against turkey rhinotracheitis pneumovirus (TRTV) induced by a fowlpox virus recombinant expressing the TRTV fusion glycoprotein (F). Vaccine 1994;12:569-573. [CrossRef]
- Lee LF, Bacon LD, Yoshida S, Yanagida N, Zhang HM, Witter RL. The efficacy of recombinant fowlpox vaccine protection against Marek’s disease: its dependence on chicken line and B haplotype. Avian Dis. 2004 Jan-Mar;48(1):129-37. [CrossRef]
- Bayliss CD, Peters RW, Cook JK, Reece RL, Howes K, Binns MM, et al. A recombinant fowlpox virus that expressed the VP2 antigen of infectious bursal disease virus induces protection against mortality caused by the virus. Arch. Virol. 1991;120:193-205. [CrossRef]
- Fahey KJ, Erny K, Crooks J. A conformational immunogen on VP2 of infectious bursal disease virus that induce virus-neutralizing antibodies that passively protect chickens. J. Gen. Virol. 1989;70:1473-1481. [CrossRef]
- Laidlaw SM, Skinner MA. Comparison of the genome sequence of FP9, an attenuated, tissue culture-adapted European strain of Fowlpox virus, with those of those virulent American and European viruses. J. Gen. Virol. 2004;85:305-322. [CrossRef]
- Shaw I, Davison TF. Protection from IBDV-induced bursal damage by a recombinant fowlpox vaccine, fpIBD1, is dependent on the titre of challenge virus and chicken genotype. Vaccine 2000;18:3230-3241. [CrossRef]
- Schneider K, Puehler F, Baeuerle D, Elvers S, Staeheli P, Kaspers B, et al. cDNA cloning of biologically active chicken interleukin-18. J Interferon Cyt. Res. 2000;20:879-883. [CrossRef]
- Afonso CL, Tulman ER, Lu Z, Zsak L, Kutish GF, Rock DL. The genome of fowlpox virus. J. Virol. 2000;74:3815-3831. [CrossRef]
- Laidlaw S.M., Anwar M.A., Thomas W., Green P., Shaw K., Skinner M.A. Fowlpox virus encodes nonessential homologs of cellular alpha-SNAP, PC- 1, and an orphan human homolog of a secreted nematode protein. J. Virol. 1998;72:6742-6751. [CrossRef]
- Nooruzzaman M, Hossain I, Rahman MM, Uddin AJ, Mustari A, Parvin R, Chowdhury EH, Islam MR. Comparative pathogenicity of infectious bursal disease viruses of three different genotypes. Microb Pathog. 2022 Aug;169:105641. [CrossRef]
- Trapp J, Rautenschlein S. Infectious bursal disease virus’ interferences with host immune cells: what do we know? Avian Pathol. 2022 Aug;51(4):303-316. [CrossRef]
- Wyatt LS, Earl PL, Moss B. Generation of Recombinant Vaccinia Viruses. Curr Protoc Protein Sci. 2017 Aug 1;89:5.13.1-5.13.18. [CrossRef]
- Rothwell CJ, Vervelde L, Davison TF. Identification of chicken Bu-1 alloantigens using the monoclonal antibody AV20. Vet Immunol Immunopathol. 1996;55:225-234. [CrossRef]
- Techera C, Tomás G, Panzera Y, Banda A, Perbolianachis P, Pérez R, Marandino A. Development of real-time PCR assays for single and simultaneous detection of infectious bursal disease virus and chicken anemia virus. Mol Cell Probes. 2019 Feb;43:58-63. [CrossRef]
- Bayliss CD, Spies U, Shaw K, Peters RW, Papageorgiou A, Muller H, et al.. A comparison of the sequence of segment A of four infectious bursal disease virus strains and identification of a variable region in the VP2. J. Gen. Virol. 1990;71:1303–1312. [CrossRef]
- Muskett JC, Hopkins IG, Edwards KR, Thornton DH. Comparison of two infectious bursal disease strains: efficacy and potential hazards in susceptible and maternally immune birds. Vet. Rec. 1979;104:332-334. [CrossRef]
- Degen WG, Daal Nv, Rothwell L, Kaiser P, Schijns VE. Th1/Th2 polarization by viral and helminth infection in birds. Vet Microbiol. 2005 Feb 25;105(3-4):163-7. [CrossRef]
- Eldaghayes I, Rothwell L, Williams A, Withers D, Balu S, Davison F, Kaiser P. Infectious bursal disease virus: strains that differ in virulence differentially modulate the innate immune response to infection in the chicken bursa. Viral Immunol. 2006 Spring;19(1):83-91. [CrossRef]
- Gelb J, Eidson CS, Fletcher OJ, Kleven SH. Studies on interferon induction by infectious bursal disease virus (IBDV). II. Interferon production in White Leghorn chickens infected with an attenuated or pathogenic isolant of IBDV. Avian Dis. 1979 Jul-Sep;23(3):634-45. [CrossRef]
- Rautenschlein S, Yeh HY, Sharma JM. Comparative immunopathogenesis of mild, intermediate, and virulent strains of classic infectious bursal disease virus. Avian Dis. 2003 Jan-Mar;47(1):66-78. [CrossRef]
- Bagheri S, Paudel S, Wijewardana V, Kangethe RT, Cattoli G, Hess M, Liebhart D, Mitra T. Production of interferon gamma and interleukin 17A in chicken T-cell subpopulations hallmarks the stimulation with live, irradiated and killed avian pathogenic Escherichia coli. Dev Comp Immunol. 2022 Aug;133:104408. [CrossRef]
- Alkie TN, Rautenschlein S. Infectious bursal disease virus in poultry: current status and future prospects. Vet Med (Auckl). 2016 Jan 19;7:9-18. [CrossRef]
- Dey S, Pathak DC, Ramamurthy N, Maity HK, Chellappa MM. Infectious bursal disease virus in chickens: prevalence, impact, and management strategies. Vet Med (Auckl). 2019 Aug 5;10:85-97. [CrossRef]
- Haygreen EA, Kaiser P, Burgess SC, Davison TF. In ovo DNA immunisation followed by a recombinant fowlpox boost is fully protective to challenge with virulent IBDV. Vaccine. 2006 Jun 5;24(23):4951-61. [CrossRef]
- Vervelde L, Davison TF. Comparison of the in situ changes in lymphoid cells during infection with infectious bursal disease virus in chickens of different ages. Avian Pathol. 1997;26(4):803-21. [CrossRef]
- Dai M, Xu C, Chen W, Liao M. Progress on chicken T cell immunity to viruses. Cell Mol Life Sci. 2019 Jul;76(14):2779-2788. [CrossRef]
- Heine HG, Boyle DB. Infectious bursal disease virus structural protein VP2 expressed by a fowlpox virus recombinant confers protection against disease in chickens. Arch Virol. 1993;131(3-4):277-92. [CrossRef]
- Lee MS, Doong SR, Lai SY, Ho JY, Wang MY. Processing of infectious bursal disease virus (IBDV) polyprotein and self-assembly of IBDV-like particles in Hi-5 cells. Biotechnol Prog. 2006 May-Jun;22(3):763-9. [CrossRef]
- Gibson MS, Steyn A, Kealy D, Kaspers B, Fife MS. Molecular cloning and characterisation of chicken IL-18 binding protein. Dev Comp Immunol. 2021 Jan;114:103850. [CrossRef]

| Virus | Final concentration (pfu/ml) |
|---|---|
| fpIBD1 | 1X109 |
| fpIBD1Δ073 | 2X109 |
| fpIBD1Δ214 | 1X109 |
| fpIBD1::IL-18 | 2X108 |
| fpIBD1Δ073::IL-18 | 2X108 |
| fpIBD1Δ214::IL-18 | 3X108 |
| Room | Group | Treatment | No. of birds |
|---|---|---|---|
| 1 | 1 | Unvaccinated and unchallenged (negative control) | 3 |
| 2 | 2 | Unvaccinated and challenged (positive control) | 7 |
| 3 | 3 | Vaccinated with fpIBD1 and challenged | 7 |
| 4 | Vaccinated with fpIBD1Δ073 and challenged | 7 | |
| 5 | Vaccinated with fpIBD1Δ214 and challenged | 7 | |
| 6 | Vaccinated with fpIBD1::IL18 and challenged | 7 | |
| 7 | Vaccinated with fpIBD1Δ073::IL18 and challenged | 7 | |
| 8 | Vaccinated with fpIBD1Δ214::IL-18 and challenged | 7 | |
| 4 | 9 | Vaccinated with fpIBD1 | 3 |
| 10 | Vaccinated with fpIBD1Δ073 | 3 | |
| 11 | Vaccinated with fpIBD1Δ214 | 3 | |
| 12 | Vaccinated with fpIBD1::IL18 | 3 | |
| 13 | Vaccinated with fpIBD1Δ073::IL18 | 3 | |
| 14 | Vaccinated with fpIBD1Δ214::IL-18 | 3 |
| RNA target | Primer/Probe* | Sequence (5′-3′) |
|---|---|---|
| 28S | F | GGC GAA GCC AGA GGA AAC T |
| R | GAC GAC CGA TTT GCA CGT C | |
| Probe | AGG ACC GCT ACG GAC CTC CAC CA | |
| IBDV (VP2) | F | GAG GTG GCC GAC CTC AAC T |
| R | AGC CCG GAT TAT GTC TTT GAA G | |
| Probe | TCC CCT GAA GAT TGC AGG AGC ATT TG |
| Vaccination | IBDV challenge | Bursal Damage Score | |||||
|---|---|---|---|---|---|---|---|
| 0 | 1 | 2 | 3 | 4 | 5 | ||
| - | - | 5 | - | - | - | - | - |
| - | + | - | - | - | 1 | 3 | 1 |
| fpIBD1 | + | 1 | 3 | 1 | - | - | - |
| fpIBD1Δ073 | + | 2 | 2 | 1 | - | - | - |
| fpIBD1Δ214 | + | 4 | 1 | - | - | - | - |
| fpIBD1::IL-18 | + | 5 | - | - | - | - | - |
| fpIBD1Δ073::IL-18 | + | 5 | - | - | - | - | - |
| fpIBD1Δ214::IL-18 | + | 5 | - | - | - | - | - |
Disclaimer/Publisher’s Note: The statements, opinions and data contained in all publications are solely those of the individual author(s) and contributor(s) and not of MDPI and/or the editor(s). MDPI and/or the editor(s) disclaim responsibility for any injury to people or property resulting from any ideas, methods, instructions or products referred to in the content. |
© 2023 by the authors. Licensee MDPI, Basel, Switzerland. This article is an open access article distributed under the terms and conditions of the Creative Commons Attribution (CC BY) license (http://creativecommons.org/licenses/by/4.0/).
